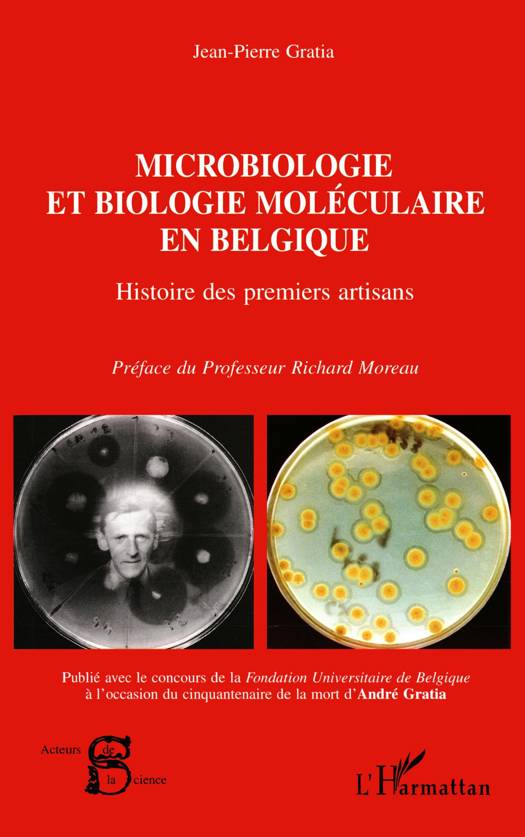

- Retrait en 2 heures
- Assortiment impressionnant
- Paiement sécurisé
- Toujours un magasin près de chez vous
- Retrait en 2 heures
- Assortiment impressionnant
- Paiement sécurisé
- Toujours un magasin près de chez vous


MICROBIOLOGIE ET BIOLOGIE MOLECULAIRE EN Belgique
Histoire des premiers artisans
Jean-Pierre Gratia
Livre broché | Français
24,00 €
+ 48 points
Description
Le professeur André Gratia fut l'un des maîtres de la microbiologie belge connu surtout pour ses travaux sur les bactériophages. Parti de l'histoire scientifique de son père, Jean-Pierre Gratia a brossé un tableau résumant l'influence souvent spectaculaire mais mal connue des travaux belges francophones des cinquante premières années du vingtième siècle sur les aspects les plus fondamentaux de la microbiologie.
Spécifications
Parties prenantes
- Auteur(s) :
- Editeur:
Contenu
- Nombre de pages :
- 232
- Langue:
- Français
Caractéristiques
- EAN:
- 9782747509732
- Date de parution :
- 01-11-03
- Format:
- Livre broché
- Dimensions :
- 135 mm x 215 mm
- Poids :
- 276 g

Seulement chez Librairie Club
+ 48 points sur votre carte client de Librairie Club
Les avis
Nous publions uniquement les avis qui respectent les conditions requises. Consultez nos conditions pour les avis.